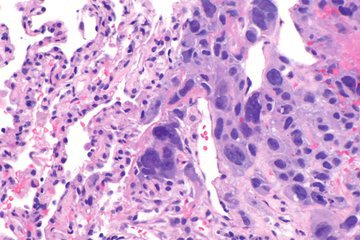
Врачи Мясников: удалять щитовидку из-за узла не обязательно

Онколог Елкин: изменение цвета и размера папилломы указывает на рак
 Здоровье
Здоровье
 Здоровье
Здоровье
Доктор Антон Елкин заявил, что в большинстве своем папилломы не несут большой опасности, однако в некоторых случаях лучше проконсультироваться с врачом, поскольку они могут переродиться в рак.
Врач Янг: мясо с овощами укрепляют кости и мышцы после 60 лет
 Здоровье
Здоровье
 Здоровье
Здоровье
Доктор Екатерина Янг в своем телеграм-канале проинформировала, как рекомендуется питаться россиянам после 60 лет.
- Гастроэнтеролог Кашух: латте вреднее эспрессо из-за сахара
- Врач Крашкина: избавиться от тревоги осенью помогут йога и хобби
- Врач Драпкина составила ТОП-5 правил долгой и здоровой жизни
- Терапевт Омарова: вегетарианство защищает от рака и улучшает здоровье кожи
- Эндокринолог Тананакина: кроме мяса, белок можно получить из орехов и тофу
- Диетолог Мухина: черный виноград защищает от рака
- Нутрициолог Антонюк: злоупотребление солью ведет к хрупкости костей
- Продеус: сосудосуживающие капли используются не дольше 3-5 дней
- Малышева раскрыла пользу от шаурмы: лук борется с микробами
- Терапевт Кондрахин: боль в спине в пожилом возрасте указывает на инфаркт
Врач Провоторова: прививка от гриппа противопоказана при аллергиии на куриное яйцо
 Здоровье
Здоровье
 Здоровье
Здоровье
Доктор Маргарита Провоторова рассказала, кому не стоит вакцинироваться от гриппа, несмотря на распространенность заболевания в осенне-зимний период. Об этом сообщает «Доктор Питер».
Нутрициолог Молчанова: киви, цитрусовые и рыба защищают от простуд
 Здоровье
Здоровье
 Здоровье
Здоровье
Эксперт Ксения Молчанова рассказала о важности потребления правильных продуктов, насыщенных витаминами и минералами, для защиты от простуд в осенний период.
Врачи Мясников: удалять щитовидку из-за узла не обязательно
 Здоровье
Здоровье
Здоровье
Здоровье
Телеведущий Александр Мясников пригласил в программу «О самом главном» хирурга Вячеслава Шибитова, который рассказал, в каком случае нужно удалять щитовидную железу, а в каком - нет.
Профпатолог Барнацкая: сон осенью улучшится в прохладной спальне
 Здоровье
Здоровье
 Здоровье
Здоровье
Доктор Светлана Бурнацкая проинформировала, как справиться с проблемами со сном с наступлением осенне-зимнего периода, когда световой день сокращается, а вставать по утрам становится все сложнее.
- Врач Сережина: защититься от ОРВИ осенью помогут физические нагрузки
- Терапевт Никулина: в борьбе с бессонницей нужно читать при неярком свете
- Врач Горовой: искривленная носовая перегородка приводит к проблемам с сердцем
- Невролог Панков: кофе и алкоголь вызывают бессонницу у пожилых
- Оториноларинголог Балакин: отит при ОРВИ приводит к тугоухости
- Нутрициолог Веселова призвала употреблять сезонные яблоки с кожурой
- Ортопед Шохирев: «утиная» походка требует срочного обращения к врачу
- Врач Мясников: куриный бульон при ОРВИ облегчает симптомы
- Эндокринолог Тананакина: диабетикам чернику можно есть в малых количествах
- Диетолог Мещерякова: перестроить рацион на осень помогут глинтвейн и чаи

